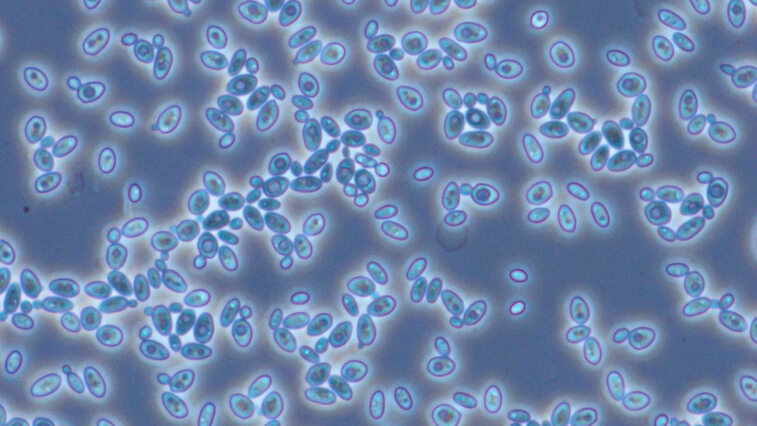
Image

News and Insights from the Zwingenberg R&D Site
25.06.2026
CRISPR Technology & Licensing

Technology
Show Article
25.03.2026
Custom enzyme panels for rapid screening in industrial Biocatalysis

Technology
Show Article
10.02.2026
Biotechnology as an enabler for the next generation of food and beverages

Technology
Show Article
18.12.2025
Methanol-free and scalable: An industry ready protein production system in Komagataella phaffii (Pichia pastoris)

Technology
Show Article
26.11.2025
CRISPR-BMC driven genome editing of robust industrial yeasts
Technology
Show Article
20.10.2025
Protecting innovation: Intellectual property management in biotechnology

Business
Show Article
09.10.2025
Methanol-free K. phaffii (P. pastoris) system for scalable, cost-effective industrial protein production

Technology
Show Article
01.09.2025
Novel enzyme discovery via MetXtra: delivering industrial enzyme breakthroughs

Technology
Show Article
26.08.2025
Biotechnology: versatile, colorful, and not just red

Business
Show Article